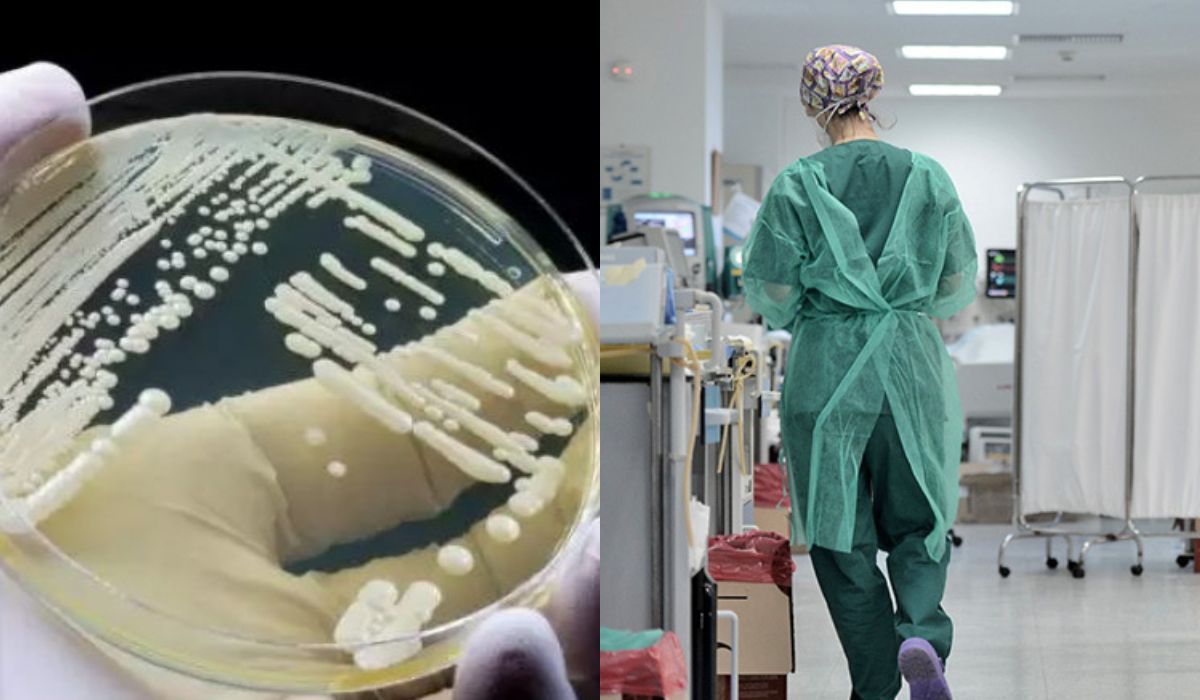
Candida auris : Σήμα κινδύνου για την νέα λοίμωξη που σκοτώνει

Candida auris: Σήμα κινδύνου για τη νέα ενδονοσοκομειακή απειλή που σκοτώνει.
Τον Μάιο του 2022 και ενώ όλος ο κόσμος επιχειρούσε να ανακάμψει από την πανδημία του κορωνοϊού, μέλη της Ελληνικής Εταιρείας Λοιμώξεων ανέφεραν σε Συνέντευξη Τύπου ένα μικροοργανισμό που το ευρύ κοινό δεν είχε ακούσει ξανά, ενώ τα χαρακτηριστικά του παρέμεναν εν πολλοίς άγνωστα και για τους επιστήμονες. Ο λόγος για την Candida auris, έναν μύκητα που εξαπλώνεται με ταχύ ρυθμό στα νοσοκομεία, ταυτοποιείται δύσκολα με αποτέλεσμα να…διαφεύγει και προσθέτει ακόμη μια πρόκληση στον «πόλεμο» των ενδονοσοκομειακών λοιμώξεων.
Το τελευταίο διάστημα πολλαπλασιάζονται τα διεθνή δημοσιεύματα που χτυπούν «καμπανάκι» για την αύξηση του πληθυσμού των μυκήτων και τη δυναμική τους να απειλήσουν την ανθρώπινη υγεία. Δύο ειδικοί στους οποίους απευθύνθηκε το ygeiamou.gr επιχειρούν να απαντήσουν στο ερώτημα: «Είναι οι μύκητες γενικότερα και η Candida auris συγκεκριμένα, η νέα απειλή;».
Όπως σημειώνει η Βιολόγος PhD και Επιδημιολόγος πεδίου του τμήματος μικροβιακής αντοχής και λοιμώξεων που συνδέονται με φροντίδα υγείας του ΕΟΔΥ, Λήδα Πολίτη, η Candida auris είναι ένα αναδυόμενο παθογόνο που περιγράφηκε πρώτη φορά το 2009 στην Ιαπωνία. Αναδρομικές μελέτες έδειξαν την κυκλοφορία του ήδη από το 2008, ενώ σύμφωνα με ακόμη νεότερες μελέτες από το εξωτερικό ο μύκητας ενδεχομένως κυκλοφορεί ήδη από το 1996 αλλά επειδή είναι δύσκολος στην ταυτοποίηση δεν ήταν γνωστός. Καταγράφονταν δηλαδή λοιμώξεις στα νοσοκομεία, αλλά δεν ήξεραν οι επιστήμονες ότι ανήκουν σε αυτό το είδος μύκητα.
Δείτε επίσης : Σαλαμίνα : Η καταδίκη σε βάρος του 71χρονου και η αποκάλυψη για τις δύο ταυτότητες του
Η Candida auris συγκεντρώνει τρία χαρακτηριστικά – μειονεκτήματα. Το πρώτο, όπως προαναφέρθηκε, είναι η δυσκολία ταυτοποίησης. Το δεύτερο είναι η αυξανόμενη αντοχή που παρουσιάζει στα αντιμυκητικά φάρμακα. Το τρίτο είναι η ευκολία με την οποία μπορεί να επιμείνει και να εξαπλωθεί εντός χώρων υγειονομικής περίθαλψης, καθιστώντας καίριας σημασίας τη λήψη μέτρων πρόληψης κι ελέγχου της διασποράς. «Τα είδη των μυκήτων είναι πάρα πολλά.
Τα είδη Candida αποτελούν διεθνώς την 4η κατά σειρά αιτία ενδονοσοκομειακών λοιμώξεων. Ένα από τα υποείδη είναι η Candida auris», σημειώνει η κυρία Πολίτη.
Στα ελληνικά νοσοκομεία, καταγράφηκε ένα περιστατικό αποικισμού από τον συγκεκριμένο μύκητα για πρώτη φορά το 2019. Η επιδημιολογική διερεύνηση δεν έδειξε περαιτέρω διασπορά του παθογόνου. Αργότερα μέσα στο 2019 εντοπίστηκε ακόμη ένα περιστατικό. «Από τότε και κατά τη διάρκεια της πανδημίας ξεκίνησε και επεκτάθηκε η διασπορά», αναφέρει η κυρία Πολίτη, εξηγώντας ότι αυτό το είδος μύκητα δεν ανήκε στα υποχρεωτικώς δηλούμενα παθογόνα από τα νοσοκομεία, τα οποία επιτηρούνται και συνεπώς υπάρχουν στατιστικά στοιχεία για αυτά. Εντάχθηκε σε αυτή τη λίστα το 2022 και πλέον καταγράφεται.
Το 2019 και 2020 οι καταγραφές περιστατικών γίνονταν μέσω ενεργητικής αναζήτησης. Το 2021, όμως, σχεδιάστηκε ειδικό σύστημα επιτήρησης για το μύκητα αυτό στον ΕΟΔΥ, το οποίο εφαρμόστηκε αρχικά πιλοτικά και πλέον εφαρμόζεται κανονικά. Σύμφωνα με τα δεδομένα που υπάρχουν στον ΕΟΔΥ, από τον Νοέμβριο του 2019 έως και τον Αύγουστο του 2023, έχουν δηλωθεί 794 κρούσματα Candida auris από 51 νοσοκομεία της Ελλάδας. «Αφορούν κυρίως σε αποικισμούς αλλά και σε διεισδυτικές λοιμώξεις. Μας ενδιαφέρουν κυρίως οι διεισδυτικές λοιμώξεις, δηλαδή όταν απομονώνεται το παθογόνο σε βιολογικό υλικό που θα έπρεπε να είναι άσηπτο. Από απλό αποικισμό δεν κινδυνεύει συνήθως κάποιος», επισημαίνει η κυρία Πολίτη.
Δείτε επίσης : Στην Αράχωβα κλιμάκιο της Δίωξης Εγκλημάτων κατά Ζωής, για τον Όλιβερ – Δεν θα γίνει εκταφή του χάσκι
Αξίζει να σημειωθεί ότι η Candida auris μεταδίδεται από τις μολυσμένες επιφάνειες και όχι από τον αέρα, συνεπώς κορωνίδα της πρόληψης εξάπλωσής της είναι η υγιεινή των χεριών, ο σωστός χειρισμός των ασθενών και ο σχολαστικός καθαρισμός των επιφανειών και των ιατρικών συσκευών.
«Οι μύκητες παρουσιάζουν μια ραγδαία εξάπλωση λόγω αύξησης της θερμοκρασίας. Αγαπούν τη ζέστη και την υγρασία, οπότε η κλιματική αλλαγή τους έχει βοηθήσει», προσθέτει η επιδημιολόγος πεδίου του ΕΟΔΥ. Χωρίς να μπορεί να προβλεφθεί το μέλλον για τις ενδονοσοκομειακές λοιμώξεις από το συγκεκριμένο μύκητα, αυτό που είναι σίγουρο, όπως λέει, είναι «η προσθήκη ακόμη ενός παθογόνου στην ήδη επιβαρυμένη κατάσταση των νοσοκομείων».
Στην εκτίμηση ότι είναι δύσκολο, με βάση τα υπάρχοντα δεδομένα, να γίνουν οι μύκητες γενικά η μεγαλύτερη απειλή των δημόσιων νοσοκομείων, προχωρά ο Καθηγητής Παθολογίας – Λοιμωξιολογίας, Διευθυντής της Α’ Παθολογικής Κλινικής του ΑΧΕΠΑ, Συμεών Μεταλλίδης.
Παραδέχεται, ωστόσο, ότι είναι ένα φαινόμενο που απαιτεί προσοχή. «Οι μύκητες αποτελούν 3ο έως 5ο αίτιο ενδονοσοκομειακών λοιμώξεων διεθνώς. Στην ελληνική επικράτεια είναι 6η ή 7η αιτία των λοιμώξεων μέσα στα νοσοκομεία. Όσο η νοσηλεία του ασθενή αυξάνεται σε χρόνο, τόσο αυξάνεται και η επίπτωση», σημειώνει, εξηγώντας ότι μεγαλύτερο πρόβλημα αντιμετωπίζουν άνθρωποι με χειρότερη ανταπόκριση του ανοσοποιητικού τους, όπως είναι ηλικιωμένοι ή άτομα με υποκείμενα νοσήματα. «Δεν υπάρχει λόγος για πανικός», λέει ο ίδιος, εστιάζοντας στην επαγρύπνηση. Στο πλαίσιο αυτό, δύο προγράμματα που είναι σε εξέλιξη στη χώρα μας για την καταπολέμηση των ενδονοσοκομειακών λοιμώξεων εστιάζουν σε μέτρα απολύμανσης, απομόνωσης ασθενών αλλά και εκπαίδευση επαγγελματιών υγείας στην υγιεινή των χεριών.
Δείτε επίσης : Διακοπή Ρεύματος ΔΕΗ : Διακοπές ρεύματος το Σάββατο (9/12/2023 ) στην Αττική
Σε ό,τι αφορά στην επικινδυνότητα της Candida auris, ο κ. Μεταλλίδης σημειώνει ότι δεν είναι περισσότερο επικίνδυνος μύκητας σε σχέση με άλλους μύκητες, αλλά «είναι πιο δύσκολος να τον βρούμε. Έχουμε καλλιέργειες που βγαίνουν αρνητικές. Σε τέτοιες περιπτώσεις προχωράμε σε εμπειρική αντιμυκητιασική αγωγή. Βάσει της εμπειρίας μας δηλαδή χορηγούμε φάρμακα που θεωρούμε ότι είναι κατάλληλα. Επίσης, η Candida auris είναι πιο ανθεκτική στην αγωγή, επομένως απαιτεί καλύτερα μέτρα».